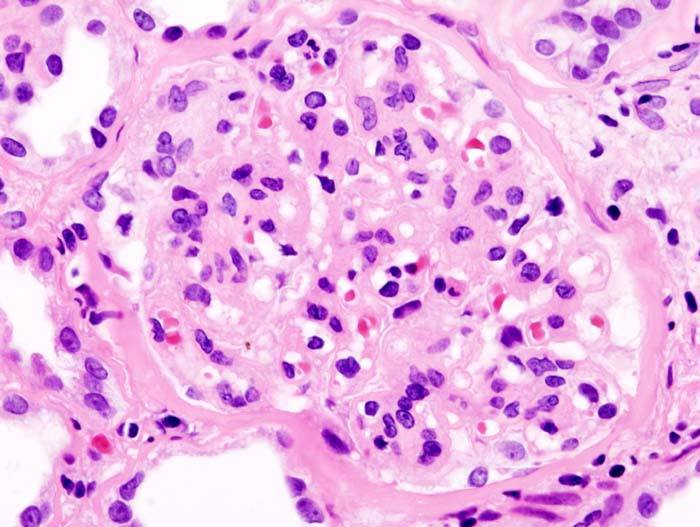

Nefropatia diabetică este o complicație frecventă a diabetului. Evoluția este inițial insidioasă până la stadii foarte avansate, însă atunci când este simptomatică, nefropatia diabetică este deja într-un stadiu foarte avansat. Prin urmare, este obligatoriu ca la toți pacieții diabetici să se evalueze, cel puțin o dată pe an, funcția renală. Depistată din timp, nefropatia diabetică și factorii de risc asociați beneficiază de tratament specific pentru a se opri progresia bolii.
• FACTORI DE RISC: Riscul de a dezvolta acestă complicație crește cu vechimea diabetului, echilibrul glicemic și prezența altor factori de risc (hipertensiune arteriala, infecții urinare recurente, litiază renală, dislipidemie, obezitate, patologie prostatică simptomatică în cazul bărbaților, prezența retinopatiei diabetice).[1]
• ANALIZE DE URINĂ: Pentru a stabili un dagnostic de nefropatie diabetică este necesară analiza urinii, care poate fi reprezentată fie de raportul albumină-creatinină urinară, fie dozarea proteinuriei din urina pe 24 ore. Prezența albuminei în urină, peste un anumit prag, persistentă și la repetarea analizei după 1-3 luni, certifică constituirea nefropatiei diabetice.
•
ATENȚIE!!! – există și cauze independente de diabet care pot duce la apariția albuminuriei (febră, efort fizic intens, sarcină, infecție urinară, ortostatism prelungit, anumite medicamente, valori foarte crescute ale tensiunii arteriale înaintea recoltării probei, alte boli independente de diabet). Pentru a stabili cu exactitate un diagnostic de nefroptie diabetică este necesară interpretarea analizelor de către medic.
• ANALIZE DE SÂNGE: Totodată, este necesară și dozarea creatininei și ureei din sânge și calcularea ratei filtrării glomerulare (RFG). În cazul în care există modificări evidente ale valorilor creatininei și ureei în sânge este posibil ca boala renală să fie mai avansată (stadiile 4 și 5) și urmărirea de către medicul nefrolog este necesară.
Bibliografie:
1. Viswanathan V, Tilak P, Kumpatla S. Risk factors associated with the development of overt nephropathy in type 2 diabetes patients: a 12 years observational. Indian J Med Res. 2012; 136(1):46-53.